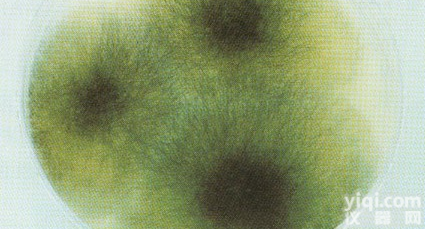
<em>绿色</em>木霉=木<em>素木</em>霉<em>说明书</em>

先使微生物在极低温度(-70℃左右)下快速冷冻,然后在减压下利用升华现象除去水分(真空干燥)。有些方法如滤纸保藏法、液氮保藏法和冷冻干燥保藏法等均需使用保护剂来制备细胞悬液,以防止因冷冻或水分不断升华对细胞的损害。保护性溶质可通过氢和离子键对水和细胞所产生的亲和力来稳定细胞成分的构型。保护剂有牛乳、血清、糖类、甘油、二甲亚砜等。
信号通路Wnt4抗体WDR61WD重复膜蛋白61抗体
信号通路Wnt6抗体WISP3Wnt1信号通路蛋白3抗体
WD重复膜蛋白61抗体WASP湿疹血小板减少伴免疫缺陷综合征相关蛋白抗体
Wnt1信号通路蛋白3抗体WDR68WDR68蛋白抗体
湿疹血小板减少伴免疫缺陷综合征相关蛋白抗体WDR91WDR91蛋白抗体
WDR68蛋白抗体WFDC5P53应答基因蛋白5抗体
WDR91蛋白抗体WDR19WD重复膜蛋白19抗体
P53应答基因蛋白5抗体Phospho-Wee1磷酸化WEE1蛋白抗体
WD重复膜蛋白19抗体WBSCR14糖类应答元件结合蛋白ChREBP抗体
磷酸化WEE1蛋白抗体Wilms Tumor Protein肾母细胞瘤蛋白抗体
糖类应答元件结合蛋白ChREBP抗体Wnt16信号通路Wnt16抗体
肾母细胞瘤蛋白抗体WDR23WDR23蛋白抗体
信号通路Wnt16抗体TCAB1端粒酶卡哈尔体蛋白抗体
WDR23蛋白抗体WNT10B信号通路WNT10B抗体
端粒酶卡哈尔体蛋白抗体WAPLEBV核蛋白2抗体
信号通路WNT10B抗体Wnt receptorWnt信号受体蛋白抗体
EBV核蛋白2抗体WAVE 1富含脯氨酸同源蛋白1抗体
Wnt信号受体蛋白抗体PPM1D原癌基因WIP1抗体
富含脯氨酸同源蛋白1抗体WNT2B信号通路Wnt2B抗体
原癌基因WIP1抗体WEE1 proteinWEE1蛋白抗体
信号通路Wnt2B抗体WRCH-1WRCH1抗体
WEE1蛋白抗体WNK3 protein丝氨酸/苏氨酸激酶家族成员的基因WNK3抗体
WRCH1抗体WNT9A信号通路Wnt9a抗体
丝氨酸/苏氨酸激酶家族成员的基因WNK3抗体WISP1Wnt1信号通路蛋白1抗体
信号通路Wnt9a抗体WIPF2WASP结合蛋白抗体
Wnt1信号通路蛋白1抗体PAG608野生型P53诱导基因1抗体
WASP结合蛋白抗体WASF3Verprolin同源结构域包含蛋白3抗体
野生型P53诱导基因1抗体Wnt11信号通路Wnt11抗体
Verprolin同源结构域包含蛋白3抗体WD SOCS box protein 2信号传导YZ蛋白WD重复蛋白2抗体
信号通路Wnt11抗体WWP1WW结构域E3泛素连接酶1抗体
信号传导YZ蛋白WD重复蛋白2抗体WDR16WD重复蛋白16抗体
WW结构域E3泛素连接酶1抗体WNK1赖氨酸缺陷型蛋白激酶1抗体
WD重复蛋白16抗体Phospho-Wee1磷酸化WEE1蛋白抗体
赖氨酸缺陷型蛋白激酶1抗体WIF1Wnt信号YZ因子1抗体
磷酸化WEE1蛋白抗体WISP2结缔组织生长因子样蛋白抗体
Wnt信号YZ因子1抗体WNT7A原癌基因wnt7a蛋白抗体
结缔组织生长因子样蛋白抗体WNT10A信号通路WNT10A抗体
原癌基因wnt7a蛋白抗体WNT信号通路Wnt5a抗体
信号通路WNT10A抗体WISP39p21调控蛋白WISP39抗体
信号通路Wnt5a抗体PAG608野生型P53诱导基因1抗体
p21调控蛋白WISP39抗体WDR26心肌缺血预处理正调节蛋白2抗体
野生型P53诱导基因1抗体WFS1Wolfram综合征蛋白1抗体
心肌缺血预处理正调节蛋白2抗体Phospho-WNK1磷酸化赖氨酸缺陷型蛋白激酶1抗体
Wolfram综合征蛋白1抗体WNK4WNK4抗体
磷酸化赖氨酸缺陷型蛋白激酶1抗体WWOX包含氧化还原酶的WW域抗体
WNK4抗体WRB色氨酸丰富蛋白抗体
包含氧化还原酶的WW域抗体XRCC1X射线修复交叉互补蛋白抗体
绿色木霉=木素木霉使用说明书色氨酸丰富蛋白抗体XPCDNA补充修复XPC细胞蛋白抗体
X射线修复交叉互补蛋白抗体XPBDNA损伤修复酶ERCC3蛋白抗体
DNA补充修复XPC细胞蛋白抗体XRCC3X射线修复交叉互补蛋白3抗体
DNA损伤修复酶ERCC3蛋白抗体XRCC4X射线修复交叉互补蛋白4抗体
X射线修复交叉互补蛋白3抗体XTP4乙型肝炎病毒X蛋白反转录蛋白4抗体
X射线修复交叉互补蛋白4抗体CCBR1钙离子通道阻端耐药蛋白CCBR1抗体
乙型肝炎病毒X蛋白反转录蛋白4抗体XIAPX-连锁凋亡蛋白/性连锁凋亡YZ蛋白抗体